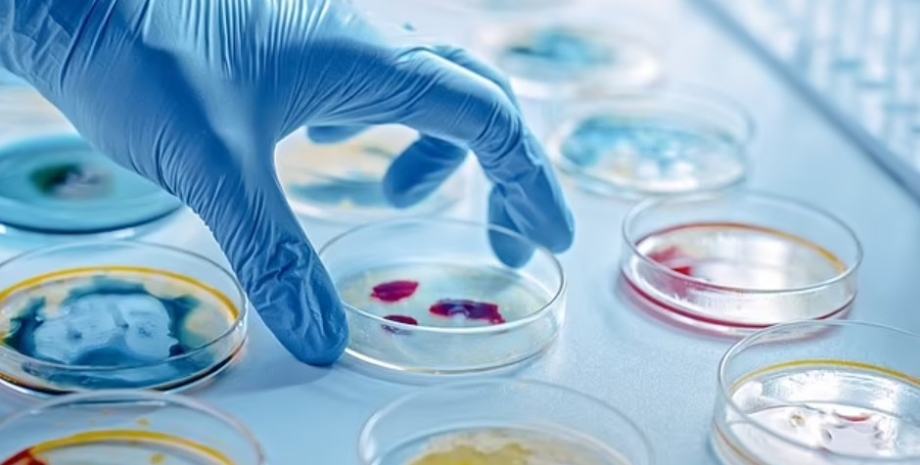

Технології та наука Найдавніші витоки раку: вчені виявили зомбі-віруси, що знищують наш організм донині
Стародавні ретровіруси давно відомі науці і їхні залишки в тому чи іншому вигляді залишаються в нашому організмі протягом сотень тисяч років. Однак нове дослідження показало, що ці залишки зовсім не є генетичним сміттям, а діють як підступні диверсанти.
Related video
Дослідники з Університету Колорадо розкрили значну роль, яку стародавні послідовності вірусної ДНК відіграють у сучасній біології раку. Про несподіване відкриття залишків стародавніх зомбі-вірусів, які продовжують позначатися на нашому здоров'ї пише ScienceAlert.
У Фокус.Технології з'явився свій Telegram-канал. Підписуйтесь, щоб не пропускати найсвіжіші та найцікавіші новини зі світу науки!
Біоінформатик Атма Іванчевич та її команда виявили, що ці залишки, відомі як ендогенні ретровіруси (ERV), які раніше вважалися неактивними, можуть бути реактивовані в ракових клітинах. Це відкриття показує, як стародавні вірусні інфекції продовжують впливати на хвороби сьогодні.
Важливо Намагалися замкнути всередині: у Німеччині знайшли могилу зомбі віком 4200 років
ERVs — це фрагменти вірусної ДНК, вбудовані в наші геноми, які передаються з покоління в покоління. Тривалий час їх вважали "небажаною" і залишковою ДНК, але останні дослідження показали, що вони можуть ставати активними і впливати на експресію генів. Ці стародавні вірусні послідовності зіграли найважливішу роль в еволюції ссавців, зокрема в розвитку плаценти.
Геномний біолог Едвард Чуонг, старший автор дослідження, опублікованого в журналі Scinece Advences, пояснює, що ракові клітини часто експресують гени, які мали б бути неактивними, і багато хто з перемикачів, відповідальних за цю аномальну експресію, походять від стародавніх вірусів.
Команда Іванчевич проаналізувала епігеномні дані щодо 21 різновиду раку і виявила високу активність конкретного сімейства ERV — LTR10. LTR10, що походить від вірусу, який заразив приматів близько 30 мільйонів років тому, регулює експресію генів у пухлинах.
Функціональні дослідження тканин колоректального раку показали, що LTR10 контролює гени, залучені в пухлинний ріст. Коли ці гени LTR10 були інактивовані в клітинах колоректальних пухлин людини і мишей, активність генів, що спричиняють рак, зокрема XRCC4, знижувалася. Ця деактивація зробила лікування раку більш ефективним, що дає змогу припустити, що LTR10 діє як епігенетичний перемикач, який регулює гени, пов'язані з раком.
Дослідники виявили, що ракові пухлини використовують ці стародавні вірусні частини для зміни патерну експресії генів у пухлинах, причому один LTR10 регулює до 70 генів, пов'язаних із раком. Хоча вони визначили гени, які регулює LTR10, вони не змогли підтвердити їхню безпосередню роль у конкретних видах раку.
Вони рекомендують продовжити дослідження з використанням органоїдів, отриманих від пацієнтів, щоб вивчити ці зв'язки. З віком реактивація цих зомбі-вірусів може сприяти виникненню інших проблем зі здоров'ям, оскільки наші захисні сили слабшають, вважають учені.
Це дослідження проливає світло на маловідомі аспекти нашої біології та їхній вплив на такі складні захворювання, як рак. Ще одним цікавим аспектом, що поглиблює розуміння ролі ERV у біології людини, є те, як вони впливають на нашу імунну систему в довгостроковій перспективі. Було показано, що ERV відіграють роль в імунних реакціях, іноді навіть захищаючи організм від інфекцій, викликаних іншими вірусами. Взаємодія між стародавньою вірусною ДНК і нашою імунною системою — це постійна сфера досліджень, що дає змогу зрозуміти як еволюційну біологію, так і потенційні терапевтичні можливості з лікування важких захворювань, вважають автори.
Раніше Фокус писав про стародавній вірус, що прокинувся в нашому організмі і викликає рак мозку. Сплячий мільйони років вірус прокинувся всередині нашого мозку, стимулюючи зростання агресивних пухлин, але згідно з новим дослідженням, у нас є надія на ліки.
Також Фокус писав про те, звідки останнім часом з'являється стільки вірусів. Наразі налічується близько 1,67 мільйона вірусів, що заражають ссавців і птахів, які ще належить ідентифікувати. Вважається, що до 827 000 з них здатні заразити людину.
Цей матеріал має виключно інформаційний характер і не містить порад, які можуть вплинути на ваше здоров'я. Якщо ви відчуваєте проблеми, зверніться до фахівця.